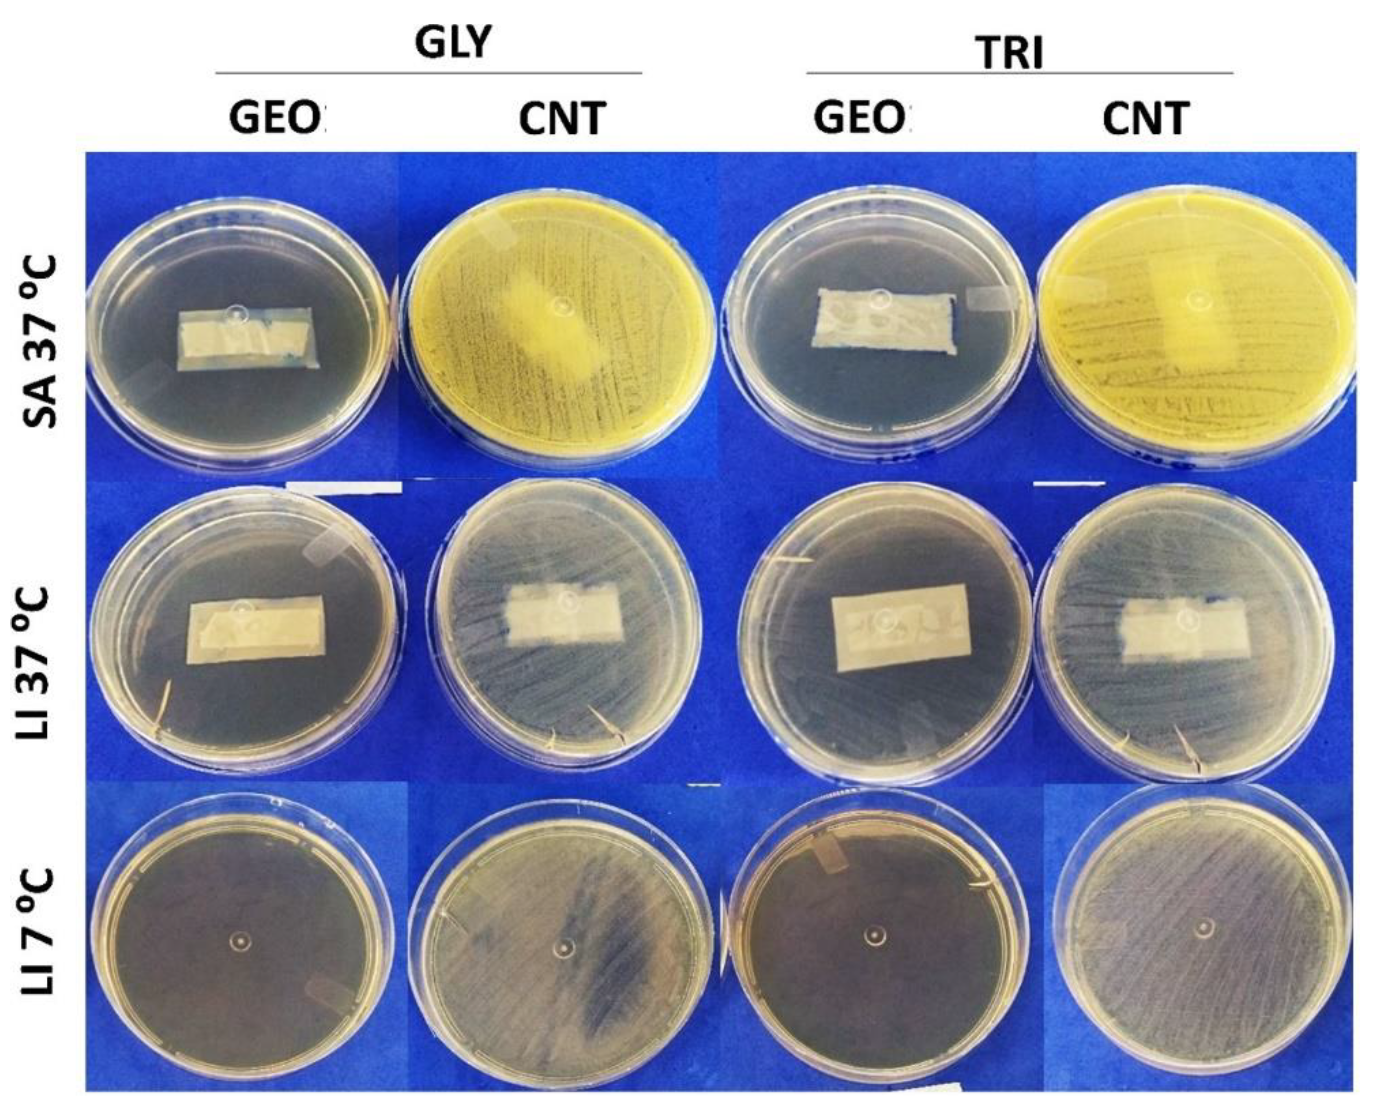
Polysaccharides 03 00016 g004

Development and Investigation of Zein and Cellulose Acetate Polymer Blends Incorporated with Garlic Essential Oil and β-Cyclodextrin for Potential Food Packaging Application
Abstract
:1. Introduction
2. Materials and Methods
2.1. Materials
2.2. Preparation of Geo:βCD Inclusion Complex
2.3. Characterization of Inclusion Complex
2.3.1. Entrapment Efficiency (EE%)
2.3.2. Thermal Stability
2.3.3. X-ray Diffraction (XRD)
2.4. Elaboration of Polymer Blends
2.5. Characterization of Polymer Blends
2.5.1. Scanning Electron Microscopy
2.5.2. Thickness and Mechanical Properties
2.5.3. Water Vapor Permeability (WVP)
2.6. Investigation of Antibacterial Properties
2.6.1. Inocula Preparation
2.6.2. Minimal Inhibitory Concentration (MIC)
2.6.3. Film Antibacterial Activity by Indirect Contact
2.7. Statistical Analysis
3. Results and Discussion
3.1. Inclusion Complex Characterization
3.2. Polymer Blends Aspect
3.3. Thermogravimetric Analysis
3.4. Mechanical and Water Vapor Barrier Properties
3.5. Antibacterial Investigation
4. Conclusions
Supplementary Materials
Author Contributions
Funding
Institutional Review Board Statement
Informed Consent Statement
Acknowledgments
Conflicts of Interest
References
- Kato, L.S.; Conte-Junior, C.A. Safety of plastic food packaging: The challenges about non-intentionally added-substances (NIAS) discovery, identification and risk assessment. Polymers 2021, 13, 2077. [Google Scholar] [CrossRef] [PubMed]
- Mangaraj, S.; Yadav, A.; Bal, L.M.; Dash, S.K.; Mahanti, N.K. Application of Biodegradable Polymers in Food Packaging Industry: A Comprehensive Review. J. Packag. Technol. Res. 2019, 3, 77–96. [Google Scholar] [CrossRef]
- Oliveira, T.V.; Freitas, P.A.V.; Pola, C.C.; Silva, J.O.R.; Diaz, L.D.A.; Ferreira, S.O.; Soares, N.F.F. Development and optimization of antimicrobial active films produced with a reinforced and compatibilized biodegradable polymers. Food Packag. Shelf. Life 2020, 24, 100459. [Google Scholar] [CrossRef]
- Gonçalves, S.M.; Santos, D.C.; Motta, J.F.G.; Santos, R.R.; Chávez, D.W.H.; Melo, N.R. Structure and functional properties of cellulose acetate incorporated with glycerol. Carbohydr. Polym. 2019, 209, 190–197. [Google Scholar] [CrossRef] [PubMed]
- Dias, M.V.; Sousa, M.M.; Lara, B.R.B.; Azevedo, V.M.; Soares, N.F.F.; Borges, S.V.; Queiroz, F. Thermal and morphological properties and kinetics of diffusion of antimicrobial films on food and a simulant. Food Packag. Shelf. Life 2018, 16, 15–22. [Google Scholar] [CrossRef]
- Pola, C.C.; Medeiros, E.A.A.; Pereira, O.L.; Souza, V.G.L.; Otoni, C.G.; Camilloto, G.P.; Soares, N.F.F. Cellulose acetate active films incorporated with oregano (Origanum vulgare) essential oil and organophilic montmorillonite clay control the growth of phytopathogenic fungi. Food Packag. Shelf. Life 2016, 9, 69–78. [Google Scholar] [CrossRef]
- Malm, M.; Liceaga, A.M.; San Martin-Gonzalez, F.; Jones, O.G.; Garcia-Bravo, J.M.; Kaplan, I. Development of Chitosan Filmsfrom Edible Crickets and Their Performance as a Bio-Based Food Packaging Material. Polysaccharides 2021, 2, 744–758. [Google Scholar] [CrossRef]
- Atta, O.M.; Manan, S.; Shahzad, A.; Ul-Islam, M.; Ullah, M.W.; Yang, G. Biobased materials for active packaging: A review. Food Hydrocoll. 2022, 125, 107419. [Google Scholar] [CrossRef]
- Atta, O.M.; Manan, S.; Ul-Islam, M.; Ahmed, A.A.Q.; Ullah, M.W.; Yang, G. Development and characterization of plant oil-incorporated carboxymethyl cellulose/bacterial cellulose/glycerol-based antimicrobial edible films for food packaging applications. Adv. Compos. Hybrid. Mater. 2022, 1–17. [Google Scholar] [CrossRef]
- Yuvarai, D.; Iyyappan, J.; Gnanasekaran, R.; Ishwarya, G.; Harshini, R.P.; Dhithya, V.; Chandran, M.; Kanishka, V.; Gomathi, K. Advances in bio food packaging—An overview. Heliyon 2021, 7, e07998. [Google Scholar] [CrossRef] [PubMed]
- Aytac, Z.; Huang, R.; Vaze, N.; Xu, T.; Eitzer, B.D.; Krol, W.; MacQueen, K.A.; Chang, H.; Bousfield, D.W.; Chan-Park, M.B.; et al. Development of Biodegradable and Antimicrobial Electrospun Zein Fibers for Food Packaging. ACS Sustain. Chem. Eng. 2020, 8, 15354–15365. [Google Scholar] [CrossRef]
- US Food and Drug Administration. Available online: https://www.cfsanappsexternal.fda.gov/scripts/fdcc/index.cfm?set=FCN&id=2043&sort=FCN_No&order=DESC&startrow=1&type=basic&search=cellulose%20acetate (accessed on 20 January 2022).
- US Food and Drug Administration. Available online: https://www.accessdata.fda.gov/scripts/cdrh/cfdocs/cfcfr/CFRSearch.cfm?fr=184.1984 (accessed on 20 January 2022).
- Lara, B.R.B.; Andrade, P.S.; Guimarães Junior, M.; Dias, M.V.; Alcântara, L.A.P. Novel Whey Protein Isolate/Polyvinyl Biocomposite for Packaging: Improvement of Mechanical and Water Barrier Properties by Incorporation of Nano-silica. J. Polym. Environ. 2021, 29, 2397–2408. [Google Scholar] [CrossRef]
- Moraes, A.R.F.; Pola, C.C.; Bilck, A.P.; Yamashita, F.; Tronto, J.; Medeiros, E.A.A.; Soares, N.F.F. Starch, cellulose acetate and polyester biodegradable sheets: Effect of composition and processing conditions. Mater. Sci. Eng. C 2017, 78, 932–941. [Google Scholar] [CrossRef]
- Sanyang, M.L.; Sapuan, S.M.; Jawaid, M.; Ishak, M.R.; Sahari, J. Effect of plasticizer type and concentration on physical properties of biodegradable films based on sugar palm (Arenga pinnata) starch for food packaging. J. Food Sci. Technol. 2016, 53, 326–336. [Google Scholar] [CrossRef] [PubMed] [Green Version]
- Teixeira, S.C.; Silva, R.R.A.; Oliveira, T.V.; Stringheta, P.C.; Pinto, M.R.M.; Soares, N.F.F. Glycerol and triethyl citrate plasticizer effects on molecular, thermal, mechanical, and barrier properties of cellulose acetate films. Food Biosci. 2021, 42, 101202. [Google Scholar] [CrossRef]
- Arruda, T.R.; Marques, C.S.; Soares, N.F.F. Native Cyclodextrins and Their Derivatives as Potential Additives for Food Packaging: A Review. Polysaccharides 2021, 2, 825–842. [Google Scholar] [CrossRef]
- Ayala-Zavala, J.F.; González-Aguilar, G.A. Optimizing the use of garlic oil as antimicrobial agent on fresh-cut tomato through a controlled release system. J. Food Sci. 2010, 75, M398–M405. [Google Scholar] [CrossRef] [PubMed]
- Marques, C.S.; Carvalho, S.G.; Bertoli, L.D.; Villanova, J.C.O.; Pinheiro, P.F.; dos Santos, D.C.M.; Yoshida, M.I.; Freitas, J.C.C.; Cipriano, D.F.; Bernardes, P.C. β-Cyclodextrin inclusion complexes with essential oils: Obtention, characterization, antimicrobial activity and potential application for food preservative sachets. Food Res. Int. 2019, 119, 499–509. [Google Scholar] [CrossRef] [PubMed]
- Mukurumbira, A.R.; Shellie, R.A.; Keast, R.; Palombo, E.A.; Jadhav, S.R. Encapsulation of essential oils and their application in antimicrobial active packaging. Food Control 2022, 136, 108883. [Google Scholar] [CrossRef]
- Ali, S.; Khatri, Z.; Oh, K.W.; Ki, I.S.; Kim, S.H. Zein/cellulose acetate hybrid nanofibers: Electrospinning and characterization. Macromol. Res. 2014, 22, 971–977. [Google Scholar] [CrossRef]
- Liu, F.; Li, X.; Wang, L.; Yan, X.; Ma, D.; Liu, Z.; Liu, X. Sesamol incorporated cellulose acetate-zein composite nanofiber membrane: As efficient strategy to accelerate diabetic wound healing. Int. J. Biol. Macromol. 2020, 149, 627–638. [Google Scholar] [CrossRef]
- Hill, L.E.; Gomes, C.; Taylor, T.M. Characterization of beta-cyclodextrin inclusion complexes containing essential oils (trans-cinnamaldehyde, eugenol, cinnamon bark, and clove bud extracts) for antimicrobial delivery application. LWT-Food Sci. Technol. 2013, 51, 86–93. [Google Scholar] [CrossRef]
- ASTM. ASTM D882-12; Standard Test Method for Tensile Properties of Thin Plastic Sheeting. ASTM: West Conshohocken, PA, USA, 2012.
- ASTM. ASTM E96/E96M-10; Standard Test Method for Water Vapor Transmission of Materials. ASTM: West Conshohocken, PA, USA, 2010.
- CLSI. Methods for Dilution Antimicrobial Susceptibility Tests for Bacteria That Grow Aerobically, 9th ed.; CLSI: Wayne, PA, USA, 2012. [Google Scholar]
- R Core Team. R: A Language and Environment for Statistical Computing; R Foundation for Statistical Computing: Vienna, Austria, 2021; Available online: https://www.R-project.org/ (accessed on 20 December 2021).
- Santos, E.H.; Kamimura, J.A.; Hill, L.E.; Gomes, C.L. Characterization of carvacrol beta-cyclodextrin inclusion complexes as delivery systems for antibacterial and antioxidant applications. LWT-Food Sci. Technol. 2015, 60, 583–592. [Google Scholar] [CrossRef]
- Giordano, F.; Novak, C.; Moyano, J.R. Thermal analysis of cyclodextrins and their inclusion compounds. Thermochim. Acta 2001, 380, 123–151. [Google Scholar] [CrossRef]
- Piletti, R.; Zanetti, M.; Jung, G.; Melo, J.M.M.; Dalcanton, F.; Soares, C.; Riella, H.G.; Fiori, M.A. Microencapsulation of garlic oil by β-cyclodextrin as thermal protection method for antibacterial action. Mater. Sci. Eng. C 2019, 94, 139–149. [Google Scholar] [CrossRef] [PubMed]
- Abarca, R.L.; Rodríguez, F.J.; Guarda, A.; Galotto, M.J.; Bruna, J.E. Characterization of beta-cyclodextrin inclusion complexes containing an essential oil component. Food Chem. 2016, 196, 968–975. [Google Scholar] [CrossRef] [PubMed]
- Narayanan, G.; Boy, R.; Gupta, B.S.; Tonelli, A.E. Analytical techniques for characterizing cyclodextrins and their inclusion complexes with large and small molecular weight guest molecules. Polym. Test. 2017, 62, 402–439. [Google Scholar] [CrossRef]
- Takahashi, A.I.; Veiga, F.J.B.; Ferraz, H.G. A literature review of cyclodextrin inclusion complexes characterization—Part II: X-ray diffraction, infrared spectroscopy and nuclear magnetic resonance. Int. J. Pharm. Sci. Rev. Res. 2012, 1, 8–15. [Google Scholar]
- Iglesias Montes, M.L.; D’amico, D.A.; Manfredi, L.B.; Cyras, V.P. Effect of Natural Glyceryl Tributyrate as Plasticizer and Compatibilizer on the Performance of Bio-Based Polylactic Acid/Poly(3-Hydroxybutyrate) Blends. J. Polym. Environ. 2019, 27, 1429–1438. [Google Scholar] [CrossRef]
- Freitas, P.A.V.; Silva, R.R.A.; Oliveira, T.V.; Soares, R.R.A.; Junior, N.S.; Moraes, A.R.F.; Pires, A.C.S.; Soares, N.F.F. Development and characterization of intelligent cellulose acetate-based films using red cabbage extract for visual detection of volatile bases. LWT-Food Sci. Technol. 2020, 132, 109780. [Google Scholar] [CrossRef]
- Meister, J. Polymer Modification: Principles, Techniques and Applications, 1st ed.; CRC Press: Boca Raton, FL, USA, 2000; 914p. [Google Scholar]
- Shanks, R.A. Concepts and classification of compatibilization processes. In Compatibilization of Polymer Blends, 1st ed.; Ajitha, A.R., Thomas, S., Eds.; Elsevier: Amsterdam, The Netherlands, 2020; pp. 31–56. [Google Scholar]
- Callister, W.D., Jr.; Rethwisch, D.G. Materials Science and Engineering: An Introduction, 8th ed.; John Willey & Sons: Hoboken, NJ, USA, 2010; 992p. [Google Scholar]
- Farhan, A.; Hani, N.M. Characterization of edible packaging films based on semi-refined kappa-carrageenan plasticized with glycerol and sorbitol. Food Hydrocoll. 2017, 64, 48–58. [Google Scholar] [CrossRef]
- Togashi, Y.; Hara, M. Water vapor permeability of polypropylene. Fusion Sci. Technol. 2011, 60, 1471–1474. [Google Scholar] [CrossRef]
- Hazrol, M.D.; Sapuan, S.M.; Zainudin, E.S.; Zuhri, M.Y.M.; Abdul Wahab, N.I. Corn Starch (Zea mays) Biopolymer Plastic Reaction in Combination with Sorbitol and Glycerol. Polymers 2021, 13, 242. [Google Scholar] [CrossRef] [PubMed]
- Miranda, J.C.; Martins, T.E.A.; Veiga, F.; Ferraz, H.G. Cyclodextrins and ternary complexes: Technology to improve solubility of poorly soluble drugs. Braz. J. Pharm. Sci. 2011, 47, 665–681. [Google Scholar] [CrossRef] [Green Version]
- Przybyla, M.A.; Yilmaz, G.; Becer, R. Natural cyclodextrins and their derivatives for polymer synthesis. Polym. Chem. 2020, 11, 7582–7602. [Google Scholar] [CrossRef]
- Vazquez, R.; Nogueira, R.; Orfão, M.; Mata, J.L.; Saramago, B. Stability of triglyceride liquid films on hydrophilic and hydrophobic glasses. J. Colloid Interface Sci. 2006, 299, 274–282. [Google Scholar] [CrossRef] [PubMed]
- Rubab, M.; Shahbaz, H.M.; Olaimat, A.N.; Oh, D.H. Biosensors for Rapid and Sensitive Detection of Staphylococcus aureus in Food. Biosens. Bioelectron. 2018, 105, 49–57. [Google Scholar] [CrossRef] [PubMed]
- Hennekinne, J.A.; De Buyser, M.L.; Dragacci, S. Staphylococcus aureus and Its Food Poisoning Toxins: Characterization and Outbreak Investigation. FEMS Microbiol. Rev. 2012, 36, 815–836. [Google Scholar] [CrossRef] [PubMed] [Green Version]
- Shamloo, E.; Hosseini, H.; Moghadam, A.Z.; Larsen, H.M.; Haslberger, A.; Alebouyeh, M. Importance of Listeria Monocytogenes in Food Safety: A Review of Its Prevalence, Detection, and Antibiotic Resistance. Iran. J. Vet. Res. 2019, 20, 241–254. [Google Scholar] [PubMed]
- Friedly, E.C.; Crandall, P.G.; Ricke, S.; O’Bryan, C.A.; Martin, E.M.; Boyd, L.M. Identification of Listeria Innocua Surrogates for Listeria Monocytogenes in Hamburger Patties. J. Food Sci. 2008, 73, 174–178. [Google Scholar] [CrossRef] [PubMed]
- Münchberg, U.; Anwar, A.; Mecklenburg, S.; Jacob, C. Polysulfides as Biologically Active Ingredients of Garlic. Org. Biomol. Chem. 2007, 5, 1505–1518. [Google Scholar] [CrossRef] [PubMed]
- Arbach, M.; Santana, T.M.; Moxham, H.; Tinson, R.; Anwar, A.; Groom, M.; Hamilton, C.J. Antimicrobial Garlic-Derived Diallyl Polysulfanes: Interactions with Biological Thiols in Bacillus Subtilis. Biochim. Biophys. Acta—Gen. Subj. 2019, 1863, 1050–1058. [Google Scholar] [CrossRef] [PubMed] [Green Version]
- Bierne, H.; Cossart, P. Listeria Monocytogenes Surface Proteins: From Genome Predictions to Function. Microbiol. Mol. Biol. Rev. 2007, 71, 377–397. [Google Scholar] [CrossRef] [PubMed] [Green Version]
- Fiedler, F. Biochemistry of the Cell Surface of Listeria Strains: A Locating General View. Infection 1988, 16, S92–S97. [Google Scholar] [CrossRef] [PubMed]
- Sheng, L.; Shen, X.; Su, Y.; Xue, Y.; Gao, H.; Mendoza, M.; Green, T.; Hanrahan, I.; Zhu, M.-J. Effects of 1-Methylcyclopropene and Gaseous Ozone on Listeria Innocua Survival and Fruit Quality of Granny Smith Apples during Long-Term Commercial Cold Storage. Food Microbiol. 2022, 102, 103922. [Google Scholar] [CrossRef] [PubMed]
- Fujisawa, H.; Suma, K.; Origuchi, K.; Seki, T.; Ariga, T. Thermostability of Allicin Determined by Chemical and Biological Assays. Biosci. Biotechnol. Biochem. 2008, 72, 2877–2883. [Google Scholar] [CrossRef] [PubMed]

| Sample | Plasticizer (30% wt/wt) | Additive (10% wt/wt) |
|---|---|---|
| BL-T-CNT | Tributyrin | - |
| BL-T- βCD | Tributyrin | β-cyclodextrin |
| BL-T-GEO | Tributyrin | Garlic essential oil |
| BL-T-IC | Tributyrin | Inclusion complex |
| CA-T-CNT | Tributyrin | - |
| CA-T- βCD | Tributyrin | β-cyclodextrin |
| CA-T-GEO | Tributyrin | Garlic essential oil |
| CA-T-IC | Tributyrin | Inclusion complex |
| BL-G-CNT | Glycerol | - |
| BL-G- βCD | Glycerol | β-cyclodextrin |
| BL-G-GEO | Glycerol | Garlic essential oil |
| BL-G-IC | Glycerol | Inclusion complex |
| CA-G-CNT | Glycerol | - |
| CA-G- βCD | Glycerol | β-cyclodextrin |
| CA-G-GEO | Glycerol | Garlic essential oil |
| CA-G-IC | Glycerol | Inclusion complex |
| Sample | Thickness (µm) | TS (MPa) | E (%) | YM (Mpa) | WVP (10−10 g·Pa−1·s−1·m−1) |
|---|---|---|---|---|---|
| BL-T-CNT | 121.6 (7.8) abc | 4.7 (0.5) a | 3.3 (0.4) a | 313 (6) a | 11.9 (1.3) c |
| BL-T- βCD | 136.7 (18.1) abc | 5.1 (0.3) a | 2.6 (0.1) a | 306 (39) a | 11.8 (0.6) c |
| BL-T-GEO | 136.2 (18.5) abc | 5.9 (0.8) a | 2.7 (0.1) a | 338 (16) a | 14.0 (1.2) c |
| BL-T-IC | 250.8 (83.4) d | 5.3 (0.5) a | 3.3 (0.3) a | 283 (33) a | 27.6 (3.8) d |
| CA-T-CNT | 58.8 (4.3) a | 28.9 (4.9) c | 7.7 (0.8) b | 1203 (203) b | 4.7 (0.2) a |
| CA-T-βCD | 112.4 (46.0) abc | 16.1 (5.5) b | 2.8 (0.4) a | 969 (287) b | 10.8 (0.7) bc |
| CA-T-GEO | 66.7 (13.1) a | 29.1 (3.1) c | 6.9 (0.4) b | 1273 (97) b | 6.5 (1.5) ab |
| CA-T-IC | 155.9 (48.2) bc | 7.7 (1.7) a | 3.6 (0.5) a | 389 (52) a | 12.3 (1.9) c |
| BL-G-CNT | 122.2 (5.8) abc | np | np | np | np |
| BL-G- βCD | 180.2 (8.8) | np | np | np | np |
| BL-G-GEO | 152.2 (4.2) bc | np | np | np | np |
| BL-G-IC | 258.5 (49) d | np | np | np | np |
| CA-G-CNT | 59.4 (0.9) a | np | np | np | np |
| CA-G- βCD | 111 (3.6) abc | np | np | np | np |
| CA-G-GEO | 76.8 (4) ab | np | np | np | np |
| CA-G-IC | 182.6 (23.5) cd | np | np | np | np |
| Bacteria | MIC (µg·mL−1) | |
|---|---|---|
| GEO | IC | |
| S. aureus | 78.12 | 4800 |
| L. innocua | 156.25 | 4800 |
Publisher’s Note: MDPI stays neutral with regard to jurisdictional claims in published maps and institutional affiliations. |
© 2022 by the authors. Licensee MDPI, Basel, Switzerland. This article is an open access article distributed under the terms and conditions of the Creative Commons Attribution (CC BY) license (https://creativecommons.org/licenses/by/4.0/).
Share and Cite
Marques, C.S.; Silva, R.R.A.; Arruda, T.R.; Ferreira, A.L.V.; Oliveira, T.V.d.; Moraes, A.R.F.; Dias, M.V.; Vanetti, M.C.D.; Soares, N.d.F.F. Development and Investigation of Zein and Cellulose Acetate Polymer Blends Incorporated with Garlic Essential Oil and β-Cyclodextrin for Potential Food Packaging Application. Polysaccharides 2022, 3, 277-291. https://doi.org/10.3390/polysaccharides3010016
Marques CS, Silva RRA, Arruda TR, Ferreira ALV, Oliveira TVd, Moraes ARF, Dias MV, Vanetti MCD, Soares NdFF. Development and Investigation of Zein and Cellulose Acetate Polymer Blends Incorporated with Garlic Essential Oil and β-Cyclodextrin for Potential Food Packaging Application. Polysaccharides. 2022; 3(1):277-291. https://doi.org/10.3390/polysaccharides3010016
Chicago/Turabian StyleMarques, Clara Suprani, Rafael Resende Assis Silva, Tarsila Rodrigues Arruda, Ana Luiza Valadares Ferreira, Taíla Veloso de Oliveira, Allan Robledo Fialho Moraes, Marali Vilela Dias, Maria Cristina Dantas Vanetti, and Nilda de Fátima Ferreira Soares. 2022. "Development and Investigation of Zein and Cellulose Acetate Polymer Blends Incorporated with Garlic Essential Oil and β-Cyclodextrin for Potential Food Packaging Application" Polysaccharides 3, no. 1: 277-291. https://doi.org/10.3390/polysaccharides3010016
APA StyleMarques, C. S., Silva, R. R. A., Arruda, T. R., Ferreira, A. L. V., Oliveira, T. V. d., Moraes, A. R. F., Dias, M. V., Vanetti, M. C. D., & Soares, N. d. F. F. (2022). Development and Investigation of Zein and Cellulose Acetate Polymer Blends Incorporated with Garlic Essential Oil and β-Cyclodextrin for Potential Food Packaging Application. Polysaccharides, 3(1), 277-291. https://doi.org/10.3390/polysaccharides3010016

